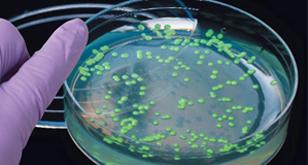

Tagged: 5.16

Genetically Modified Plants: Grade 9 Understanding for IGCSE Biology 5.15 5.16
You should understand how bacteria can be genetically modified to produce useful proteins (e.g.human insulin, human growth hormone, vaccine antigens etc.) – see previous post if you are unsure. In this post, I will try to explain how transgenic plants can be made and indeed what kind of genes might be added to plants to benefit humans. Genetically modifying a plant will be a more complex process since plants are multicellular and so many millions of cells need to be genetically altered.
Luckily a vector exists that can transfer genes into many varieties of plant. Agrobacterium tumefaciens is a species of bacterium that contains a plasmid that can be transferred into plant cells. This plasmid (called the Ti plasmid) can be cut open with a restriction enzyme and a new gene inserted with DNA ligase.

The Agrobacterium that have been genetically modified will then infect the plant tissue and then when this plant tissue is cultivated using the micropropagation techniques you learned about with cauliflower, a whole GM plant can be produced.
Genes can also be inserted into plants by a gene gun. A gene gun literally fires “bullets” made of tiny particles of gold that have been coated with the required DNA and while Agrobacterium does not infect all species of plant, the gene gun can work to get foreign DNA into any plant species.
What are the potential advantages of GM crops?
Resistance to Herbicide: some crop plants have been altered so they contain a gene that makes them resistant to a particular herbicide. This means a farmer can spray the herbicide on his crop without risk of harming the crop plant.
Resistance to Frost: some GM plants have a gene from a species of Arctic fish that codes for an “antifreeze” chemical in the fish blood. Plants that contain this gene will be frost-resistant and so produce can be transported in refrigerated containers without damaging the plant cells.
Golden Rice: rice plants have been altered so they contain genes that make the molecule beta-carotene. This is the orange pigment found in carrots and is a precursor for making vitamin A. So in populations who rely on rice as a staple component of their diet, the rice will be more nutritious and so prevent the night-blindness associated with vitamin A deficiency.
Antibody production: plants may also be genetically modified to produce antibodies for treatment of human disease.
Genetic Modification Grade 9 Understanding for IGCSE Biology 5.12 5.13 5.14 5.16
One of the most complicated areas in the iGCSE course is looking at how organisms can be genetically modified. Remember that humans have been messing around with the genetic composition of many species for thousands of years. Up until recently this has only been using a technique called selective breeding or artificial selection.
Make sure you understand exactly what is meant by the term selective breeding? You probably should be able to explain at least one example in both an animal and a plant species.
In the twentieth century scientists developed a much more precise way of genetically modifying a species. This was due to discoveries about the nature of the genetic code and also the existence of two types of enzyme that make cutting up and then sticking together pieces of DNA. This new technique was called genetic engineering and it has two big advantages over selective breeding. Firstly genes from different species can be recombined to form transgenic organisms. Transgenic is an important term and means an organism that contains DNA from more than one species. This means scientists are not restricted to alleles present in the natural population but can insert genes from any species into any other. Secondly, selective breeding has a big disadvantage in that it can reduce the allelic diversity in a population. If the population becomes more and more similar at a genetic level, this means that inbreeding becomes more of a problem and the population becomes susceptible to damage from changes in the environment.
You need to understand the role of two enzymes in the process of Genetic Engineering:
Restriction Enzymes are found in bacteria and have evolved to combat viral infection in the bacterial cell. These enzymes can cut double-stranded DNA at a specific target sequence, often leaving the ends of the DNA with short sections of unpaired bases. These are called sticky ends.
The image below shows the cutting site of a restriction enzyme called EcoR1. You can see the enzyme cuts the DNA anywhere the following sequence is found GAATTC. The DNA molecule is cut after the first G, leaving the two strands with four unpaired bases that make up the two sticky ends.
Here are some more restriction enzymes and there target sequences. The bottom three on the list all produce sticky ends.

The second important enzyme for genetic engineering is DNA Ligase. This enzyme catalyses the joining together of the sticky ends of two fragments to produce an intact DNA molecule.
The starting point for understanding the complex topic of genetic modification of organisms is understanding the role of these two enzymes in the process.







